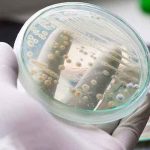
mexico

Etiqueta: candida auris
Piden investigar presencia de hongo altamente infeccioso en El Salvador
El paciente a quien a finales de enero 2020 se le detectó infección por el hongo Candida Auris en el Hospital Médico General del...
El Salvador identifica primer caso de hongo Candida Auris
Este lunes 22 de febrero, el médico Iván Solano Leiva informó a través de su cuenta de Twitter que El Salvador ya registra su...
México en alerta por la presencia de hongo mortal en pacientes de covid
México, 14 dic (Prensa Latina) La Unidad de Inteligencia Epidemiológica y Sanitaria (UIES) de la Dirección General de Epidemiología de México alertó hoy de...
Brasil detecta su primer posible caso del peligroso hongo ‘Candida auris’
Brasil ha registrado el posible primer caso positivo de infección en su territorio por el peligroso hongo 'Candida auris', que es resistente a los...
Candida auris: El misterioso hongo resistente a los medicamentos
En 2015, Johanna Rhodes, especialista en enfermedades infecciosas del Imperial College London, recibió una llamada de emergencia de un hospital a las afueras de...